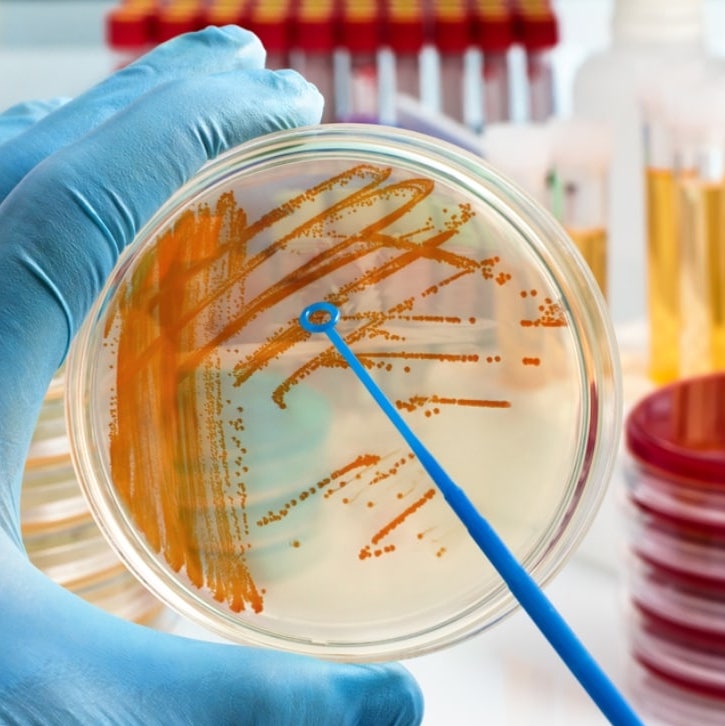

URINOCOLTURA E AROMATOGRAMMA
Rileva l’eventuale presenza di batteri e funghi patogeni
50.00€
Aggiungi al carrelloEsame colturale delle urine per la rilevazione di batteri e patogeni
Con l’urinocoltura si esegue un esame microbiologico che permette di rilevare batteri, funghi e patogeni responsabili di infezioni a carico delle vie urinarie. In caso di rilevazione di patogeni, questi vengono sottoposti ad Antibiogramma, Antimicogramma ed Aromatogramma, per definire quali medicinali o oli essenziale siano più efficaci per eliminare la carica batterica/micotica.